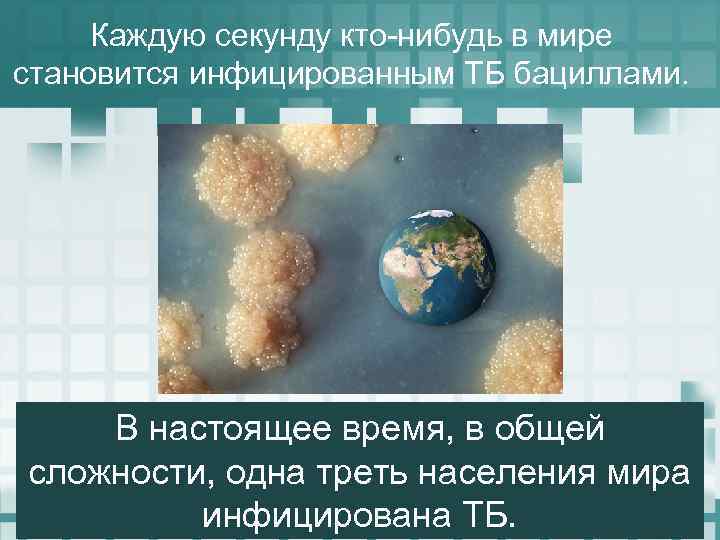

Заболевания органов дыхания.ppt
- Количество слайдов: 42

Заболевания дыхательной системы у детей

Что относится к дыхательной системе? 1. Носовая полость 2. Носоглотка 3. Трахея 4. Бронхи 5. Легкие

Виды заболеваний дыхательной системы по местоположению 1. Заболевания носовой полости 2. Заболевания ротовой полости и глотки 3. Заболевания верхних дыхательных путей 4. Заболевания нижних дыхательных путей

Форма конспектирования 1. 2. 3. 4. Определение заболевания Симптомы заболевания Лечение Профилактика

Заболевания носовой полости 1. Насморк 2. Воспаление придаточных пазух носа

Насморк это одновременно и самостоятельное заболевание, потому что насморком в быту часто называют ринит (воспаление оболочек носовой полости, от греческого «ринос» - нос), и проявление многих болезней

Затруднение дыхания заложенность носа обильные выделения

Причины: - острая респираторная инфекция - механические повреждения - аллергическая реакция на профвредности

Лекарства от насморка 1. Лекарства, увлажняющие полость носа ( созданы на основе морской воды или воды минерального источника) 2. Сосудосужающие средства ( нафтизин, галазолин, ксилометазолин, ксилен, назол, називин ) 3. Противовирусные препараты 4. Бактериальные вакцины

Насморк надо лечить ! - постоянный насморк угнетает обоняние - насморк нарушает дневное и ночное дыхание - насморк мешает общению - осложнением насморка являются проблемы со слухом, гаймориты, нижележащих отделов дыхательной системы

Правила сморкания: 1. Сморкаться надо поочереди каждой ноздрей

Не сморкайтесь слишком сильно, когда у вас заложен нос, иначе воспаление может перейти на уши

Гайморит воспалительным заболеванием, которое развивается в верхнечелюстных придаточных пазухах носа

Признаки воспаления придаточных пазух носа 1. Заложенность носа более двух недель с начала простудного заболевания 2. Головные боли, усиливающиеся при поднимании и опускании головы 3. Голос звучит глухо, ребенок говорит в нос 4. Боль при нажатии на придаточные пазухи носа или надбровные дуги

Причины: - несвоевременное лечение насморка, простуды -больные зубы -осложнения после скарлатины, гриппа и других инфекционных заболеваниях -искривления носовой перегородки -аномалии строения носовой полости


Острое респираторное заболевание группа инфекционных заболеваний верхних дыхательных путей, передающихся воздушнокапельным путем.

Ложный круп воспаление слизистой оболочки дыхательного горла и глотки, чаще всего вызванное предшествовавшей простудой или другим вирусным заболеванием

Болеют преимущественно дети до 8 лет

Симптомы ложного крупа Симптомы 1 фазы Заболевание обычно начинается внезапно: ночью появляются затрудненное дыхание, грубый, «лающий кашель» , голос сохраняется. Выражены катаральные явления, лихорадка.

Симптомы второй фазы затрудненный вдох, цианоз, ребенок беспокоен, у него выражен страх

Симптомы третьей фазы крупа резко усиливается цианоз, ребенок В этом состоянии, если мечется, покрывается холодным ребенку не оказать потом, теряет сознание, пульс немедленную помощь, могут становится аритмичным, слабого развиться судороги и наполнения. наступить смерть.

Лечение 1. Отвлекающие ножные или общие горячие ванны с температурой воды до 39— 40 °С в течение 5— 7 мин; 2. Теплое питье 3. Вертикальное положение тела и приток свежего воздуха

Помощь ребенку 1. При удушье ребенка надо посадить 2. Если ребенок еще не сидит, его надо взять на руки в вертикальное положение и поднести к окну

Ротавирусная инфекционное заболевание, вызванное ротавирусом

Циклический характер ротавирусной инфекции 1. Инкубационный период 1 -5 суток 2. Острый период – 7 суток 3. Пеариод реконвалисценции 4 -5 суток

Симптомы ротавирусной инфекции глинообразный

Механизм распространения фекально-оральный через продукты питания, особенно молочные -водопроводная вода -через грязные руки -воздушно-капельным путем -

Ангина ( частный случай тонзиллита) воспаление миндалин, вызванное бета-гемолитическим стрептококком группы А или грибками рода Кандида

Симптомы ангины t= 38 -41 градусов по Цельсию У маленьких детей: боль в горле 1. Слюнотечение Увеличение подглоточных 2. Отказ от еды лимфатических узлов 3. Сжатие зубов ( тризм жевательных мышц)

Аденоиды расположены выше миндалин, в задней части носовой полости

Воспаленные аденоиды: хроническая нехватка кислорода - неправильный прикус - вызывают воспаление ушей -

Симптомы воспаленных аденоидов 1. ребенок жалуется на то, что ему трудно дышать через нос 2. дышит через открытый рот 3. говорит в нос 4. дышит шумно 5. плохо спит и храпит во сне 6. во время сна на несколько секунд прекращает дышать 7. часто болеет простудными заболеваниями

Аденоиды удаляются через рот с помошью кюретки

Туберкулез это инфекционная болезнь легких, передающаяся по воздуху. Возбудитель палочка Коха


Воспалительный процесс при туберкулезе раз вивается очень медленно (это хроническая инфекция, длящаяся годами) и склонен к некрозу первичного очага воспаления.

Симптомы туберкулеза неспецифические Недомогание Слабость Плохой аппетит Бледность Слабость специфические - потливость в ночные и утренние часы -навязчивый длительный кашель
Каждую секунду кто-нибудь в мире становится инфицированным ТБ бациллами. В настоящее время, в общей сложности, одна треть населения мира инфицирована ТБ.


У 5% - 10% людей, инфицированных ТБ, развивается активная болезнь. Без лечения каждый человек с инфекционным ТБ ежегодно инфицирует примерно 10 -15 человек.

При отсутствии лечения смертность от активного туберкулеза доходит до 50% в течение одного-двух лет.
Заболевания органов дыхания.ppt